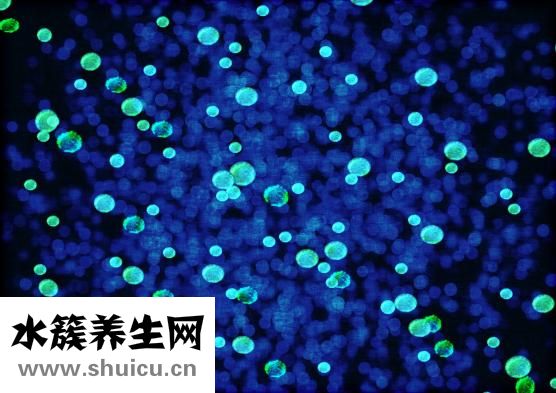
柴胡舒肝丸

柴胡舒肝丸這種藥物可能很多人都沒(méi)有聽說(shuō)過(guò),主要是因?yàn)檫@種藥物的適用范圍,想要使用這種藥物的話,建議大家應(yīng)該要對(duì)于這種藥物的服用方法有一定的認(rèn)識(shí)。我們?cè)谏钪袘?yīng)該要對(duì)于柴胡舒肝丸這種藥物的藥用價(jià)值有一定的了解,這樣我們就可以好好的利用這種藥物去治療自己的疾病了。

我們?cè)谏钪兄委熂膊∈菓?yīng)該要用到柴胡舒肝丸這種藥物,而且在生活中治療疾病的時(shí)候,我們建議大家應(yīng)該要知道它的藥用價(jià)值,這樣才能夠很好的利用柴胡舒肝丸這種藥物,因?yàn)椴窈娓瓮枋峭ㄟ^(guò)柴胡、當(dāng)歸、紅花等藥材進(jìn)行組合而成的,對(duì)于疏肝解郁、活血化瘀都有一定的作用。

柴胡舒肝丸是一種處方藥,始載于《太平惠民和劑局方》。
【組成】柴胡、黃芩、山梔、香附、青皮、木香、白芍、甘草、陳皮、川芎。
【制法】上藥、水二煎,取二升,去滓,分二服。

【主治】肝郁不舒,胸脅刺痛,脅痛吞酸,脘悶納呆。
【用法】上6藥,水二煎,去滓,分二服。
【禁忌】孕婦忌服。
【功能主治】疏肝解郁,活血化瘀。用于肝氣不舒,胸脅刺痛,脘悶吞酸,脅痛吞酸,脘悶納呆。
【用法用量】上6藥,水二煎,去滓,分二服。
【注意】肝郁不舒,胸脅刺痛吞酸者,應(yīng)選用柴胡舒肝丸加柴胡舒肝丸加柴胡舒肝丸加郁金加味。

藥物的種類是很多的,對(duì)藥物的選擇也是不能隨意的進(jìn)行,尤其是對(duì)一些藥物不了解的時(shí)候,對(duì)自身疾病治療,也是沒(méi)有任何幫助的,厄貝沙坦片也是這樣的藥物,它對(duì)治療各種疾病上,效果非常不錯(cuò),所以對(duì)它的選擇,也是...

補(bǔ)中益氣丸通常是一種中成藥物,是由多種中藥制成的藥物。一般在藥物進(jìn)行調(diào)理的時(shí)候,要在醫(yī)生的指導(dǎo)下合理的服用藥物。

瑞舒伐他汀鈣片這類藥品堅(jiān)信大伙兒都不容易生疏,主要是適用腳氣,濕疹等病癥,因此在服食瑞舒伐他汀鈣片的情況下,大伙兒最好是在醫(yī)師的具體指導(dǎo)下服食,以防給人體導(dǎo)致?lián)p害。實(shí)際的服食方式及其服食時(shí)間...

嘌呤高的食物是有哪些,要吃哪些的呢?不一樣的食材中,所帶有的嘌呤含量是不一樣的,那麼,嘌呤高的食物各自有什么呢?下邊對(duì)于這一問(wèn)題一起來(lái)開展簡(jiǎn)易的掌握和了解吧,期待以下幾點(diǎn)對(duì)大伙兒有一定的協(xié)助!...

蕁麻疹癥狀在春天起的情況下非常顯著,并且這類病癥也有輕度的發(fā)癢病癥,病癥的發(fā)展趨勢(shì)會(huì)影響到一切正常的日常生活,引起許多的病癥。因而,針對(duì)這類病癥的醫(yī)治,不但要醫(yī)治原發(fā)性病癥,也要留意對(duì)病癥的醫(yī)...

阿爾茲海默癥也是屬于老年癡呆癥的一種類型,阿爾茲海默癥是屬于記憶力的疾病,而且病程是比較長(zhǎng)的,而且隨著年齡的增長(zhǎng)病情的發(fā)展速度會(huì)越來(lái)越快,而且患者還可能會(huì)伴隨著記憶力減退,以及智能下降,記憶力...

豆?jié){是人們?cè)谏钪薪?jīng)常會(huì)食用到的一種飲品,這種飲品在飲用的時(shí)候不僅品嘗起來(lái)非常的美味,而且還含有非常豐富的營(yíng)養(yǎng)元素,其中就包括了豆?jié){當(dāng)中含有了很多的蛋白質(zhì)和維生素,經(jīng)常飲用,對(duì)于人體來(lái)說(shuō)是非...

黑咖啡這種東西在我們的生活中是比較多的,特別是對(duì)于一些老年人來(lái)說(shuō),喝黑咖啡是比較好的,主要是黑咖啡里面含有大量的咖啡因,而且黑咖啡還可以去除我們體內(nèi)的油膩,降低膽固醇的含量,而且黑咖啡還可以防...

馬齒莧主要是清熱解毒的功效,同時(shí)也具有消腫以及止痛的效果,但是在使用的時(shí)候一定要注意控制好使用的劑量,同時(shí)在用藥期間一定要注意觀察身體變化。...

蕁麻疹是一種皮膚病,它一般是因?yàn)閮?nèi)外要素而造成的,是由各種各樣要素造成的。日常生活有很多蕁麻疹病人,都遭受蕁麻疹的損害,這個(gè)時(shí)候病人務(wù)必要馬上開展醫(yī)治。蕁麻疹的誘因有很多,大部分病人由于各種...

硒是人體的生命之火,是人體內(nèi)不可缺少的營(yíng)養(yǎng)成分,生活中很多水果都含有硒元素,但你知道含硒第一名的水果是什么嗎?含硒高的水果又有哪些呢?跟水簇養(yǎng)生網(wǎng)一起來(lái)看看吧。...

一級(jí)夫妻性生活的年紀(jì)大概在20歲到50歲左右,如果是一種比較好的情況下,性生活的頻率一般在10到20分鐘左右,如果是比較差的夫妻,性生活的頻率可能會(huì)受到很多因素的影響,有些人可能會(huì)擔(dān)心,性生活的質(zhì)量不...

黃ba等中草藥可用于治療多種男科疾病。 可是不應(yīng)過(guò)多使用。 畢竟,該藥具有三點(diǎn)毒性,并且肯定會(huì)引起身體某些副作用,尤其是對(duì)腎功能的影響,將產(chǎn)生非常大的影響,因此一定應(yīng)該引起注意, 可能會(huì)繼續(xù)導(dǎo)致自...

三道鱗魚是歐美鯽魚的一種變異魚,它在人體表面的鱗片很大。所以在歐洲的一些地區(qū),經(jīng)常有人用三道鱗魚來(lái)曬蝦米作為鏡子,所以三道鱗魚也有另外一個(gè)名字,鏡魚。如今,三道鱗魚已經(jīng)被引入中國(guó)許多地區(qū)進(jìn)行...

在我們的日常生活中,桂花酒屬于一種常見的酒,具有桂花樹的香味和多種營(yíng)養(yǎng)元素,特別適合冬季飲用。桂花酒可以暖身祛寒作用,還可以合理減少疲勞功效,改善睡眠質(zhì)量等。...

許多人喜歡在冬天去釣魚。在這種情況下,米酒通常被用作巢的材料。對(duì)于一些更有經(jīng)驗(yàn)的人來(lái)說(shuō),筑巢是非常好的。然而,許多人沒(méi)有做好并死去。死亡巢穴的出現(xiàn)有很多原因。可能是制作巢料時(shí)香料的味道太...

三角肌 注射是預(yù)防接種醫(yī)院門診的重點(diǎn)工作。精確定位和選擇合適的位置對(duì)于確保安全注射非常重要。三角肌注射/的正確方式是什么?三角肌宜注射方法是將右手收緊在部分皮膚上,將無(wú)名指固定在針上,使針...

我堅(jiān)信很多人都吃過(guò)馬鮫魚,這是一種有價(jià)值的魚,營(yíng)養(yǎng)含量很高,比如蛋白質(zhì)豐富多彩。另外,馬鮫魚含有維生素A和各種礦物質(zhì)元素。據(jù)了解,食用馬鮫魚具有補(bǔ)氣養(yǎng)血的功效,還具有止咳化痰的功效。女性可以通...

夏天很多人喜歡買泥鰍吃。泥鰍有很多做法,比如蒸、炸等等。它是一種人們非常喜歡吃的食物。而且泥鰍的營(yíng)養(yǎng)價(jià)值也很高,但是每次吃的時(shí)候處理掉泥鰍是個(gè)麻煩的問(wèn)題,尤其是如果內(nèi)臟需要清理的話。所以...

相信很多人都用過(guò)上海藥皂,它是中國(guó)上海第一塊特效除菌皂,那么上海藥皂都有什么作用呢?下面就來(lái)說(shuō)說(shuō)上海藥皂的功效與作用,一起來(lái)了解下吧。...


茶葉蛋能保存幾天(雞蛋怎么保存時(shí)間長(zhǎng))

九死還魂草的功效與作用是什么 盤點(diǎn)九死還魂草的五大價(jià)值





痛風(fēng)靈多少錢一瓶 揭秘痛風(fēng)靈售價(jià)

